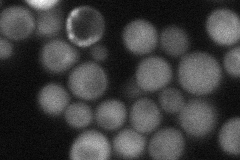
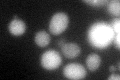
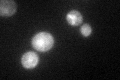

View description
Nudix hydrolase family member with ADP-ribose pyrophosphatase activity; shown to metabolize O-acetyl-ADP-ribose to AMP and acetylated ribose 5'-phosphate
Localization:
Intensity:
Fold change:
Significance:
-
C’ GFP library in SD

cytosol38.03 -
N' NOP1pr-GFP in SD

mitochondria233.436 -
N' TEF2pr-mCherry in SD

mitochondria338.567 -
N' NATIVEpr-GFP in SD
cytosol,punctate50.1339 -
N' TEF2pr-VC and Cyto-VN in SD

#N/A0 -
C’ GFP library in SD+DTT
cytosol43.071.13No -
C’ GFP library in SD+H2O2

cytosol34.940.91No -
C’ GFP library in Starvation Media
cytosol59.291.55Yes -
C’ GFP library on the background of Pup2-DaMP

cytosol -
C’ GFP library on the background of CCT mutant

cytosol33.31830.875862No
